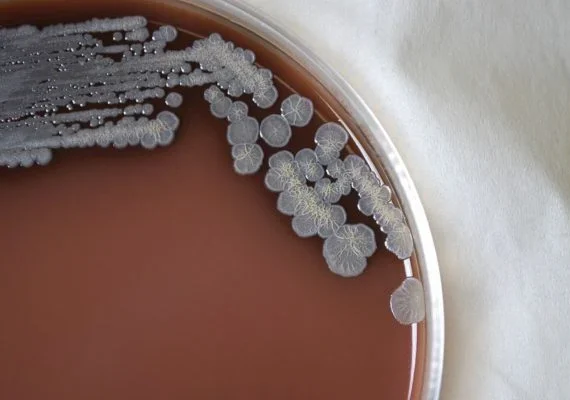
Bactéria rara encontrada nos EUA deixa autoridades de saúde em alerta

Últimas

29/07/2022 14:08 | ATENDIMENTO
INSS: análise de atestado pode ser feita via aplicativo

29/07/2022 12:57 | Economia
Taxa de desemprego cai para 9,3% no segundo trimestre

29/07/2022 11:29 | Economia
Receita Federal paga hoje restituições do 3º lote do Imposto de Renda

29/07/2022 10:29 | Política
Bolsonaro diz ao TSE que fala a embaixadores foi ‘debate de ideias’

29/07/2022 09:31 | Situação Estarrecedora
Mulher encarcerada há 17 anos com os filhos pelo marido disse que família não comia há três dias

29/07/2022 08:11 | Economia
MP libera R$ 10,9 bi para auxílios a caminhoneiros e taxistas

28/07/2022 18:09 | FICÇÃO?
Arábia Saudita quer construir cidade espelhada tecnológica no meio do deserto

28/07/2022 17:46 | DE PATO BRANCO
Mulher ganha ação de indenização por danos morais contra o cantor Gusttavo Lima

28/07/2022 16:59 | MUNDO
OMS pede redução de contato sexual entre homens como prevenção à varíola dos macacos
últimas
-
Formação de alunos e alunas
Valorização do mérito estudantil marca entrega de tablets na Rede Municipal de Arapiraca
-
Ações da SpaceX
Elon Musk se torna o primeiro bilionário a ultrapassar US$ 600 bilhões
-
Solidariedade que salva vidas
Colaboradores do Hospital da Cidade se unem em ação de doação de sangue
-
Turmas do 9º ano da rede municipal
JHC prestigia formatura unificada do 9° ano e destaca investimentos históricos na educação
-
Procurando emprego?
Unidade móvel do Sine Alagoas vai até Palmeira dos Índios e Olho D'água das Flores esta semana